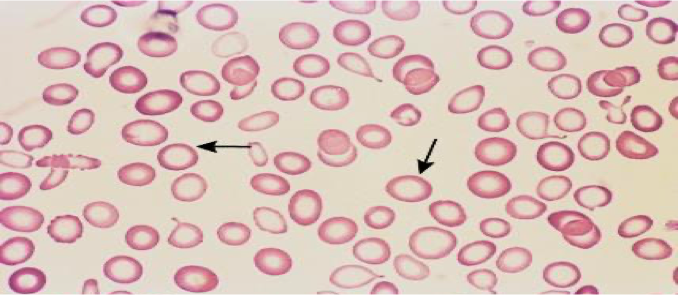

Nutritional Anemia
DR Mansour ALQurashi
Anemia
Anemia is defined as reduction in the oxygen carrying capacity leading to tissue hypoxia and results in reduction in red cell volume or hemoglobin concentration and hematocrit below normal or two standard deviations below the mean for the normal for age and sex.
WHO/UNICEF/UNO (1997 Morphological Classification)
| Morphological Classification | Microcytic Hypochromic Anemia | Normocytic Normochromic Anemia | Macrocytic Anemia |
|---|---|---|---|
| MCV | < 80 fl | 80-94 fl | > 94 fl |
| MCH | < 29 pg | 29-34 pg | N |
| MCHC | < 30% | 30-36% | N |
| ![[Nutritional Anemia-20241119110229478.webp | 520]] |
Pathophysiologic Classification of Anemia
-
Anemia due to increased blood loss:
- Acute posthemorrhagic anemia
- Chronic blood loss due to conditions like hookworm infestation, ulcerative colitis, polyps, etc.
-
Anemia due to impaired red cell production:
- Deficient heme synthesis: iron deficiency anemia
- Vitamin B₁₂ or folic acid deficiency (megaloblastic anemia)
- Deficient globin synthesis: Thalassemia
- Aplastic anemia (acquired or hereditary)
- Pure red cell aplasia
- Anemia of chronic disorders (chronic renal failure, cardiac disorders)
-
Anemia due to increased red cell destruction (hemolytic anemia):
- Sickle cell anemia, thalassemia, hemoglobinopathies
- Autoimmune hemolytic anemia
- Hereditary spherocytosis
- Paroxysmal nocturnal hemoglobinuria
Nutritional anemia arises due to the deficiency of:
- Iron
- Folate, Vitamin B12
- Proteins
- Vitamin E
- Ascorbic acid
- Other micronutrients like copper
Approach to a Case of Anemia
History
This should include enquiry about:
- The presence of chronic diseases, (especially renal), or prematurity.
- Gastrointestinal symptoms.
- Dietary history: adequate iron intake.
- Family history: relatives with inherited disorders such as sickle cell disease, thalassaemia or hereditary spherocytosis.
- Place of birth: sickle cell screening has been part of the Guthrie test.
Examination
Causes of anemia are very age-dependent and inherited anemias show a racial preponderance:
- Afro-Caribbean ancestry: sickle cell disease.
- Mediterranean and Asian ancestry: Thalassaemia.
Associated Signs
- Jaundice: suggests acute haemolysis.
- Petechiae or bruising: suggest marrow failure.
- Splenomegaly: suggests haemolysis, haemoglobinopathy or marrow failure.
Investigation
The most important initial investigation is a full blood count (FBC) to confirm reduced haemoglobin concentration and document red cell indices.
Additional valuable information from the FBC includes:
- Reticulocytes: an increase suggests haemolytic anaemia; a decrease suggests marrow aplasia.
- Pancytopenia: a reduction in all cell types suggests marrow failure or hypersplenism.
- A peripheral blood film can also reveal abnormal cells (blasts) commonly seen in leukaemias.
Depending on the initial results, further investigations might include:
- Iron studies: serum iron, ferritin and total iron binding capacity.
- Direct antiglobulin test (DAT or Coombs’ test): this is positive in immune-mediated haemolysis.
- Red cell folate, vitamin B12.
- Haemoglobin electrophoresis.
- Red cell enzymes: glucose-6-phosphate dehydrogenase (G6PD), pyruvate kinase.
- Bone marrow aspiration.
Functions of Iron
- Formulation of hemoglobin
- Formulation of cytochrome myoglobin
- Binding O2 to RBC and transport
- Regulation of Body temperature
- Muscle activity
- Catecholamine metabolism
- Immune system – ↓ T cell ↓ antibodies
- Brain Development & function
- Depressed thyroid function
Risk Factors of IDA
- Low socioeconomic status
- Prematurity and low birth weight
- Excessive milk intake
- Early introduction of cow’s milk
- Prolonged bottle feeding
- Prolonged exclusive breast feeding
- Overweight and obesity

Causes of Iron Deficiency
-
Decreased Iron Stores:
- Preterms (small for dates, twins)
-
Decreased Intake/Assimilation:
- Delayed weaning, malnutrition
- Iron poor diet
- Malabsorption syndromes, chronic diarrhea
- Gastrointestinal surgery
-
Increased Demands:
- Prematurity, low birth weight
- Infants
- Adolescents
- Recovery from protein-energy malnutrition
-
Increased Losses:
- Gastrointestinal bleeding, peptic ulcer, diverticulitis
- Meckel’s diverticulitis, polyp, hemangioma
- Pulmonary hemosiderosis
- Hookworm infestation, bleeding diathesis
- Feto-maternal hemorrhage
- Feto-fetal hemorrhage
- Repeated venous sampling
IDA Screening
- For all children, perform laboratory screening at 9 to 12 months of age.
- For children fed an iron-fortified formula, delay to 15 to 18 months of age.
- For children with risk factors for iron deficiency (e.g., history of prematurity or dietary risk factors such as excessive milk intake), test when risk is identified (at birth and 4 months), test again, e.g., at 15 to 18 months of age.
- For children with special health needs (chronic infection, inflammatory disorders, chronic gastrointestinal dysfunction, history of intestinal surgery, or restricted diets), test at 9 months, repeat laboratory screening at 15 to 18 months of age, and again in early childhood, e.g., between two to five years of age.
- For breastfed infants, iron supplement between 4-6 months of age for term infants (two weeks of age for premature infants). Iron supplements continued until the infant is taking sufficient quantities of iron-rich complementary foods, such as infant cereal.
- For all children, dietary measures include:
- Introduce iron-rich complementary foods at four to six months of age.
- Avoid unmodified (non-formula) cow’s milk until age 12 months; after 12 months of age, limit milk intake to no more than 600 mL daily (cow’s milk protein-induced colitis).
Screening
-
Screening for high risk, or mentioned diseases such as prematurity at birth and 4 months.
-
The AAP suggests universal laboratory screening for IDA at approximately 9 to 12 months of age and repeated screens for children with risk factors.
-
For children at high risk, screen once a year from ages 2 to 5 years.
Developmental Stages of Iron Deficiency Anemia
| Stage | Characteristics | Characteristics |
|---|---|---|
| 1 | Pre-latent iron deficiency | - Low ferritin - Absent bone marrow iron (exhaustion of tissue reserve of iron, asymptomatic) |
| 2 | Latent iron deficiency | - Low transferrin saturation - Low serum iron - Raised serum transferrin - Normal hemoglobin |
| 3 | Frank iron deficiency anemia | - Low hemoglobin - Low hematocrit |
Clinical Features
- Pallor.
- Fatigue, exercise intolerance, tachycardia, cardiac dilatation, and systolic murmurs.
- Splenomegaly (10%).
- Irritability and anorexia (Infants and toddlers).
- Developmental delays and behavior disturbances that may be irreversible.
- Poor growth.
- Blue sclerae, koilonychia, angular stomatitis.
- Increased susceptibility to infection.
- Iron deficiency increases lead absorption and has been associated with pica, which may result in plumbism.

Diagnostics
Hematologic Markers
- Hemoglobin: is sensitive and screening for iron deficiency. Hb and Hct are late markers of iron deficiency, are not specific for IDA.
- MCV, the average volume of RBCs: ratio of Hct to RBC count. MCV is useful for categorizing anemia as microcytic, normocytic, and macrocytic.
- Red blood cell distribution width (RDW): variations in the size of RBCs. RDW is high in iron deficiency anemia, but low in thalassemia minor.
- Reticulocyte count: circulating immature RBCs. Decreases with iron deficiency, increases with blood loss. Used for assessing the response to iron supplements.
- Reticulocyte Hb concentration (CHr): early indicator of iron deficiency. Concentration of iron-containing protein in reticulocytes, low CHr was the best predictor of iron deficiency compared with Hgb, MCV, serum iron, RDW, and transferrin saturation.
Biochemical Markers
- Ferritin: storage compound for iron. It correlates with total iron stores. As iron stores are depleted, serum ferritin levels decline and are the earliest marker of iron deficiency. <15μg/L
- Serum iron concentration: It is usually less than 30 µg/dl. Can be measured directly and generally decreases as iron stores are depleted.
- Total iron-binding capacity (TIBC): It measures the availability of iron-binding sites. Iron is transported in the body bound to transferrin, a specific carrier protein. Hence, TIBC indirectly measures transferrin levels. TIBC increases as serum iron concentration decreases. TIBC is more than 350 µg/dl.
- Serum transferrin receptor (TfR): useful as an early marker of iron deficiency. This receptor is present on reticulocytes. With tissue iron deficiency, there is a proportional increase in the number of transferrin receptors. To Differentiate Between IDA and Anemia of Chronic Disease
Peripheral Smear
- Anisocytes - unequal size of RBC.
- Poikilocytes - abnormally shaped RBC.
- Microcytic and hypochromic red cells.
Differential Diagnosis of Microcytic Hypochromic Anemia
- IDA.
- Anemia of chronic infection.
- Thalassemias.
- Lead poisoning.
- Sideroblastic anemia.
Management
Successful Management Requires:
- Confirmation of Diagnosis
- Investigations to find out the etiology and to treat the cause
- Supplementation of iron
Treatment of Cause of IDA
- Recurrent infections
- Diarrhea
- Acute respiratory infections
- Malaria
- Worm infestations
Treatments
A) Iron Therapy
B) Blood Transfusion
- Indicated only when anemia is very severe.
- Packed RBCs should be administered slowly in an amount sufficient to raise the Hb to a safe level.
- Severely anemic child with Hb less than 4 gm/dl should be given 3-5 ml/kg of packed RBCs at any one time. Diuretic furosemide 1-2 mg/kg/dose to be given between blood transfusions.
C) Prevention
Primary Prevention: Involves counseling at routine health supervision visits from infancy through adolescence to help ensure that ingestion of iron is adequate.
Secondary Prevention: Involves regular screening, prompt diagnosis, and appropriate treatment of iron deficiency.
Various approaches undertaken to prevent IDA include:
- Diet modifications
- Iron supplementation
- Food fortification
- Control of recurrent infections